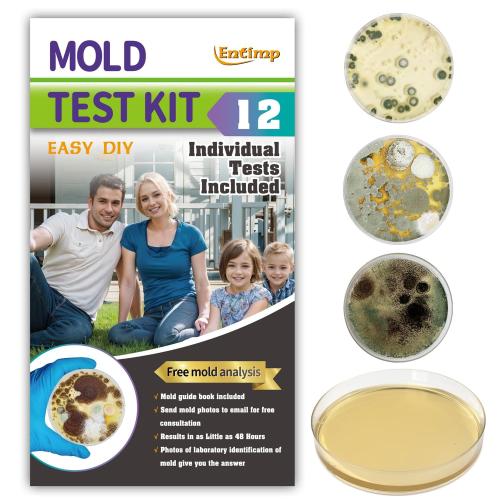
Mold Test Kit for Home Within 12 Individual Tests,DIY Detector at Home, Surface Mold,HVAC,Indoor Air Quality Testing Kits,Black Mold Testing,Includes Detailed Mold Identification Guide and Free Lab

- Starts in
NEW LOCATION NOW OPEN!
4500 Cambridge Road Suite 100 Fort Worth, TX 76155
All bids are final. No cancellations are allowed. Please bid responsibly.
Pickup is by appointment only, scheduled through our app or website.
Appointments may be rescheduled up to 48 hours before the originally scheduled time.
Missed appointments that are not rescheduled within the allowed timeframe will result in the item(s) being considered abandoned.
ITEM CONDITIONS OVERVIEW
We sell merchandise in a variety of conditions, and we want our buyers to be fully informed on what they will be getting:
- Brand New:
- The product is in brand-new condition and comes in its original packaging. It should be free from defects and complete with all parts. Please note, the packaging seal may have been opened during the inspection process. If any defects, issues, or missing parts are found in items listed as Brand New, they are eligible for an account credit. No refunds will be issued.
- Open-Box:
- The product may or may not be in its original manufacturer's packaging. Upon inspection, the item appears unused. We do not verify the count of individual parts, so the item may be missing small components like manuals, hardware, accessories, or attachments. Open-Box items are NOT eligible for credits or refunds.
- Pre-Owned:
- Upon inspection, the product shows signs of use and may be dirty, missing parts, or missing accessories. By purchasing items in Pre-Owned condition, the customer accepts the risks associated with these conditions. Pre-Owned items are NOT eligible for credits or refunds.
Thank you for being a part of our auction, and we can't wait to see you soon!
- Location
- DFW, TX
4500 Cambridge Road Suite 100 Fort Worth, TX 76155 United States
- All winning bids are subject to an additional 13% buyer's premium, and 8.25% state sales tax
.png)






![Electric Meat Grinder, Stainless Steel Sausage Stuffer Maker With 2 Blades, 3 Plates, Sausage Tube & Kubbe Kit, [2000W Max] Heavy Duty for Home Use](/uploads/cache/httpsmmediaamazoncomimagesI710GGWE6blLACSL1500jpg-500x500.jpg)













































![KEYOOG 425-364 Lower Steering Shaft Universal Rag U-Joint Coupler Fit for 2003-2006 Fo-rd Expedition [03 04 05 06 Li-ncoln Navigator ] Replaces Steering Column 2L1Z3B676AA 3L1Z3B676AA 4L1Z3B676AA](/uploads/cache/httpsmmediaamazoncomimagesI41tbjWAFyLACSL1150jpg-500x500.jpg)

































![Steam Grill Brush Bristle Free,[Ultra Safe & Efficient] Grill Cleaner for Outdoor Grill,BBQ Replaceable Scraper Cleaning Head,Grill Brush BBQ Accessories,Gifts for Men/Dad](/uploads/cache/httpsmmediaamazoncomimagesI715qBO50PZLACSL1500jpg-500x500.jpg)


































































































































![Boys of the Bowery - The East Side Kids Collection [DVD]](/uploads/cache/httpsmmediaamazoncomimagesI51Dn2rUCAiLjpg-500x500.jpg)





















































































































![Privacy Case for iPhone 16 Pro with 360°Stand [Built-in Anti Peeping Screen Protector] [Compatible with MagSafe] [Magnetic Ring ] Full Body Protective Phone Cover 6.3, Pink](/uploads/cache/httpsmmediaamazoncomimagesI715Ev0iTALACSL1500jpg-500x500.jpg)





















































































![TORRAS Shockproof for Samsung Galaxy S25 Ultra Case, [Non-Yellowing] [12FT Military-Grade Protection] Transparent Slim Case for Samsung S25 Ultra Case, Diamond Clear, Hard, 6.9'' Guardian Series](/uploads/cache/httpsmmediaamazoncomimagesI71GSBiCwOvLACSL1500jpg-500x500.jpg)





































































![Mumba Case for Nintendo Switch OLED 2021, [Thunderbolt Series] Protective Clear Cover with TPU Grip Compatible with Nintendo New Switch OLED 7 Inch Console and Joy-Con Controller (Clear)](/uploads/cache/httpsmmediaamazoncomimagesI51p7ZHOSbgLACSL1001jpg-500x500.jpg)











































![[ New Model] Replacement blender Blade for Ninja Accessories, Only Compatible with Nutri Ninja Foodi Power Blender SS150,SS151,SS300, SS350,SS351, SS351TGT, CO351B, SS100, SS101, SS101C, CO101B](/uploads/cache/httpsmmediaamazoncomimagesI71og2c8sE1LACSL1500jpg-500x500.jpg)

































![Ailun Screen Protector for iPad 11th A16 2025 [11 Inch] / 10th Generation 2022 [10.9 Inch], Tempered Glass [Face ID & Apple Pencil Compatible] Ultra Sensitive Case Friendly [2 Pack]](/uploads/cache/httpsmmediaamazoncomimagesI71nVIiWEcgLACSL1500jpg-500x500.jpg)









































![Privacy Screen Protector for iPad A16 11th/10th Generation 10.9 inch (2022/2025) 9H Tempered Glass [Face ID & Apple Pencil Compatible] HD Clear Case Friendly](/uploads/cache/httpsmmediaamazoncomimagesI61oYAWJdjgLACSL1500jpg-500x500.jpg)






![Ailun Screen Protector for iPhone 14 Plus/iPhone 13 Pro Max [6.7 Inch Display], 3 Pack Case Friendly Tempered Glass](/uploads/cache/httpsmmediaamazoncomimagesI71eUx6WUpNLACSL1500jpg-500x500.jpg)
























![Ailun Screen Protector for iPad Pro 11 inch 2025/2024 [6/5th Generation M5/M4], iPad Air 11 Inch 2025/2024 [7/6th Generation M3/M2],Tempered Glass Face ID Apple Pencil Compatible Case Friendly 2 Pack](/uploads/cache/httpsmmediaamazoncomimagesI71nfU3SNuNLACSL1500jpg-500x500.jpg)



![Ailun 3 Pack for iPhone 17 Pro Privacy Screen Protector [6.3 inch] with installation frame, Anti Spy Private Tempered Glass Anti-Scratch Case Friendly](/uploads/cache/httpsmmediaamazoncomimagesI71h1ZLa7LACSL1500jpg-500x500.jpg)















![[2 2 Pack] Privacy Screen Protector Compatible with Galaxy S25 Ultra 5G - 2 Tempered Film 2 Camera Lens Glass, High Clarity, Bubble Free, Anti-Spy Protection - Scratch Resistant](/uploads/cache/httpsmmediaamazoncomimagesI6187hcua89LACSL1500jpg-500x500.jpg)












![IMBZBK [Auto-Dust Removal] 3 Pack Privacy Screen Protector for iPhone 17 Pro Max [6.9 INCH] Anti Spy Private Accessories, Case Friendly Film, Military Grade Tempered Glass 3 Camera Lens Protector](/uploads/cache/httpsmmediaamazoncomimagesI71lnAbisDzLACSL1500jpg-500x500.jpg)


























































![Ktele Magnetic for iPhone 17 Pro Max Case [Compatible with Magsafe] [Premium Silicone Satin-Smooth Touch] Slim Shockproof Anti-Scratch Microfiber Lining Case, 6.9 inch, Matcha](/uploads/cache/httpsmmediaamazoncomimagesI61mKeWsh68LACSL1500jpg-500x500.jpg)




























-500x500.jpg)











-500x500.jpeg)










![SUNDAYSILKS™ Premium Silk Pillow Cases | 100% Mulberry Silk Pillowcase with Zipper, Real 22 Momme Grade 6A Silk, Standard Queen, King Size [Navy Blue]](/uploads/cache/httpsmmediaamazoncomimagesI81igZhEGkaLACSL1500jpg-500x500.jpg)




























































































































-500x500.jpg)







































-500x500.jpeg)
































-500x500.png)



-500x500.jpg)



















![SUNDAYSILKS™ Premium Silk Pillow Cases | 100% Mulberry Silk Pillowcase with Zipper, All Sides Real 22 Momme Grade 6A Silk, Standard Queen, King Size [Olive]](/uploads/cache/httpsmmediaamazoncomimagesI815cmwNgQOLACSL1500jpg-500x500.jpg)


















-500x500.jpg)

![Battlefield V - Steelbook [No Game Included]](/uploads/cache/httpsmmediaamazoncomimagesI713PehnFT5LSL1500jpg-500x500.jpg)




















-500x500.jpg)



























![for Tesla Model Y Juniper(2025-2026) & Model 3(2024-2026) Leather Center Console Cover [Soft Touch & Match Seat Color] Armrest Cover for Tesla Model 3 & Model Y Juniper Accessories White](/uploads/cache/httpsmmediaamazoncomimagesI71BsEI3ScnLACSL1500jpg-500x500.jpg)





![[2025 Upgraded] zestwrench Electric Knitting Machine Adapter for Addi Knitting Machine 46, LCD Panel & Row Counter, Flat/Circular Dual Mode, Variable Speed Motor Accessories for Most Yarns](/uploads/cache/httpsmmediaamazoncomimagesI81M4IZb98JLACSL1500jpg-500x500.jpg)


























































































![TONMA Fabric Scissors [Made in Japan] 12 inches Professional Tailor Sewing Scissors for Fabric Cutting, Commercial Heavy Duty Stainless Steel Dressmaking Shears for Leather, Mirror Finish](/uploads/cache/httpsmmediaamazoncomimagesI610H36UzE7LACSL1500jpg-500x500.jpg)

![CASETiFY Impact Case for iPhone 16 hf [Slim / 8.2 ft. 4X Military Grade Drop Protection/Wireless Charging Compatible] - Cheetah Paradise Pink - Clear Black](/uploads/cache/httpsmmediaamazoncomimagesI61n60niCBLACSL1000jpg-500x500.jpg)






![Pelican Voyager iPhone 17 Pro Max Case [Compatible with MagSafe] Rugged Phone Case, 24ft Military-Grade Drop Protection - Heavy Duty Cover w/Belt Clip Holster for iPhone 17 Pro Max - Black/Clear](/uploads/cache/httpsmmediaamazoncomimagesI71C9hBwkEpLACSL1500jpg-500x500.jpg)

![Lamicall Gooseneck Phone Holder Bed - [Nylon Braided] Flexible Arm, Overall Length 38inch, 360 Adjustable Clamp Clip, Overhead Cell Phone Mount Stand for Bed, Blue White](/uploads/cache/httpsmmediaamazoncomimagesI51454JCHULACSL1500jpg-500x500.jpg)









































































![9 Pack Magnetic Cable Clips [Cable Smooth Adjustable] Cord Holder, Under Desk Cable Management, JOYROOM Adhesive Wire Holder Keeper Organizer for Home Office Desk Phone Car Wall Desktop Nightstand](/uploads/cache/httpsmmediaamazoncomimagesI81yvBDKR49LACSL1500jpg-500x500.jpg)






























































































































-500x500.jpg)













































































-500x500.jpeg)

![XIRON [2 PACK] Paper Screen Protector Compatible with iPad Pro 12.9 (2022&2021&2020&2018), High Touch Sensitivity No Glare for iPad Pro 12.9 Matte Screen Protector, Compatible with Apple Pencil](/uploads/cache/httpsmmediaamazoncomimagesI71ZXioRIitLACSL1500jpg-500x500.jpg)














